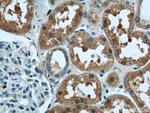
LYN Antibody in Immunohistochemistry (Paraffin) (IHC (P))

Search
Proteintech
LYN Polyclonal Antibody
{{$productOrderCtrl.translations['antibody.pdp.commerceCard.promotion.promotions']}}
{{$productOrderCtrl.translations['antibody.pdp.commerceCard.promotion.viewpromo']}}
{{$productOrderCtrl.translations['antibody.pdp.commerceCard.promotion.promocode']}}: {{promo.promoCode}} {{promo.promoTitle}} {{promo.promoDescription}}. {{$productOrderCtrl.translations['antibody.pdp.commerceCard.promotion.learnmore']}}
产品信息
18135-1-AP
种属反应
宿主/亚型
分类
类型
抗原
偶联物
形式
浓度
规格
纯化类型
保存液
内含物
保存条件
运输条件
产品详细信息
Immunogen sequence: KDITRKDAE RQLLAPGNSA GAFLIRESET LKGSFSLSVR DFDPVHGDVI KHYKIRSLDN GGYYISPRIT FPCISDMIKH YQKQADGLCR RLEKACISPK PQKPWDKDAW EIPRESIKLV KRLGAGQFGE VWMGYYNNST KVAVKTLKPG TMSVQAFLEE ANLMKTLQHD KLVRLYAVVT REEPIYIITE YMAKGSLLDF LKSDEGGKVL LPKLIDFSAQ IAEGMAYIER KNYIHRDLRA ANVLVSESLM CKIADFGLAR VIEDNEYTAR EGAKFPIKWT APEAINFGCF TIKSDVWSFG ILLYEIVTYG KIPYPGRTNA DVMTALSQGY RMPRVENCPD ELYDIMKMCW KEKAEERPTF DYLQSVLDDF YTATEGQYQQ QP (132-512 aa encoded by BC075002)
靶标信息
Lyn proto oncogene (Lcl/Yes related novel protein tyrosine kinase) is encoded by the Lyn gene located on chromosome 8 in humans and belongs to the Src family kinase. It is a non-receptor tyrosine kinase that acts as a mediator in transducing cellular signaling. The most well studied expression of Lyn is in hematopoietic cell types, both lymphoid and myeloid cells with exclusion in T lymphocytes. It has also been observed that Lyn plays diverse roles such as in regulation of B cell receptor signaling, mast cell signaling and Epithelial - Mesenchymal Transition (EMT).
仅用于科研。不用于诊断过程。未经明确授权不得转售。
生物信息学
蛋白别名: FLJ26625; Lck/Yes-related novel protein tyrosine kinase; lyn tyrosine kinase; p53Lyn; p56Lyn; Tyrosine-protein kinase Lyn; unnamed protein product; V-yes-1 Yamaguchi sarcoma viral related oncogene homolog
基因别名: JTK8; LYN; p53Lyn; p56Lyn; SAIDV
UniProt ID: (Human) P07948
Entrez Gene ID: (Human) 4067